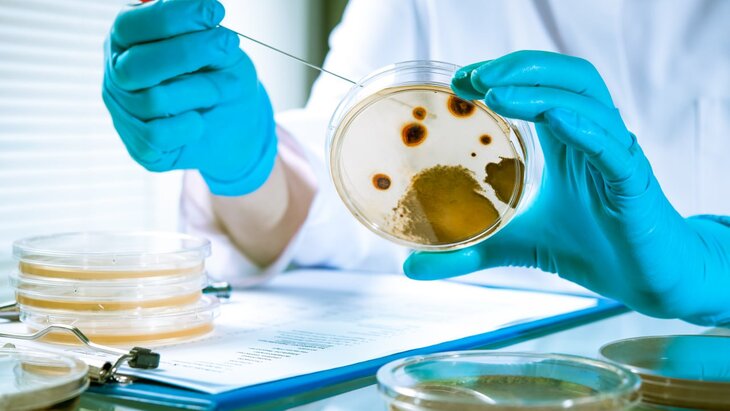

29 мая 2023, 17:27
ПолитикаВ Госдуме создана рабочая группа по вопросам биобезопасности – СМИ
Фото: depositphotos/alexraths
В Госдуме создана рабочая группа по вопросам биобезопасности, сообщает РИА Новости со ссылкой на информированный источник.
"В Госдуме образована межфракционная рабочая группа по вопросам биобезопасности", – отмечается в сообщении.
Согласно положению о рабочей группе, заседания должны проходить не менее одного раза в полгода.
По словам спикера, в группу вошли вице-спикер Госдумы Ирина Яровая, глава комитета ГД по охране здоровья Дмитрий Хубезов, глава комитета ГД по безопасности Василий Пискарев, а также глава комитета ГД по обороне Андрей Картаполов.
В сентябре 2022 года министр иностранных дел Российской Федерации Сергей Лавров заявил, что МИД РФ и Роспотребнадзор ведут совместную работу по противодействию угрозам биобезопасности.
Лавров отметил, что российское министерство иностранных дел и Роспотребнадзор сообща решают сложнейшие задачи, включая эпидемиологические задачи и угрозы биобезопасности, которые в последнее время приобретают военное измерение.
Песков заявил, что РФ намерена привлечь внимание мира к деятельности биолабораторий США








 Собянин рассказал об обновлении колледжей имени И. А. Лихачева и "Царицыно"
Собянин рассказал об обновлении колледжей имени И. А. Лихачева и "Царицыно"



















